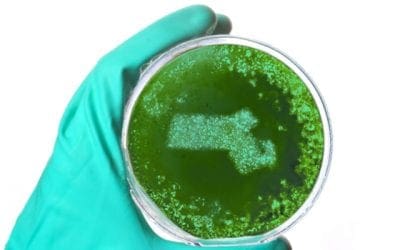
15 Massachusetts Life Science Companies That Spend the Most on R&D | BioSpace

Gemini News & Updates
Featured News:
No Results Found
The page you requested could not be found. Try refining your search, or use the navigation above to locate the post.
Industry News:
No Results Found
The page you requested could not be found. Try refining your search, or use the navigation above to locate the post.
Company News:
PhRMA Highlights Impact of Cell and Gene Therapies in New Report | BioSpace
Very interesting read that dives into how the current pharmaceutical landscape is evolving based on the impact and success of cell and gene therapies. Many of these new research pioneers are right in our backyard here in Beantown! This morning the Pharmaceutical...
5 Advantages of Looking for a New Job Over the Holidays | BioSpace
We couldn’t agree more! If you’re interested in making a career move now or in early 2019, but don’t know where to begin, we’re here to help. Many job seekers take it for granted that the holidays are not the best time to be on the job market, so they suspend their...
Holiday Greetings from Junior and Gemini Staffing!
Our tree is officially up at the Gemini office! Our buddy Junior is excited to ring in the holiday season with belly rubs and new job openings!
Massachusetts doctors going the startup route – The Boston Globe
The Greater Boston Area is ripe with both hospitals and pharmaceutical companies; and doctors have an essential role in both. Interesting read about the differences each path may offer to incoming MDs into the workforce, and why so many are considering choosing...
The 2018 Top Places to Work in Massachusetts – The Boston Globe
Congratulations to all who made the list this year! Exciting to see so many of our clients making a strong showing while representing the pharmaceutical industry in MA. These 128 businesses have the happiest employees in the state, according to our survey. Here are...
5 Advantages of Looking for a New Job Over the Holidays | BioSpace
We love this article, it couldn’t be more true right now! We are definitely feeling the push for those skilled in data management, clinical operations, and medical writing as companies begin to look into rounding out 2018, and planning ahead for the new year. It’s...
15 Massachusetts Life Science Companies That Spend the Most on R&D | BioSpace
It’s fascinating to see these MA based pharmaceutical companies, both small and large, spending as much as 72% of their budget on Research and Development efforts. Interesting read! Boston Business Journal recently created a list of 15 Massachusetts life science...
2018’s Fiercest Women in Life Sciences | FiercePharma
A huge congratulations goes out to all of the hard working women who are paving the way for future professional females in the pharmaceutical arena! In the Greater Boston Area and abroad, you are an inspiration to us all. Despite advances in life sciences and the...
Pan-Mass Challenge Announces Unprecedented $56 Million Gift to Dana-Farber Cancer Institute | BioSpace
Congratulations to all of our clients, consultants, and friends who were a part of such an amazing event this year! These record breaking results are coming at such an exciting time for cancer research in Genetown. The Pan-Mass Challenge (PMC) today announced the...